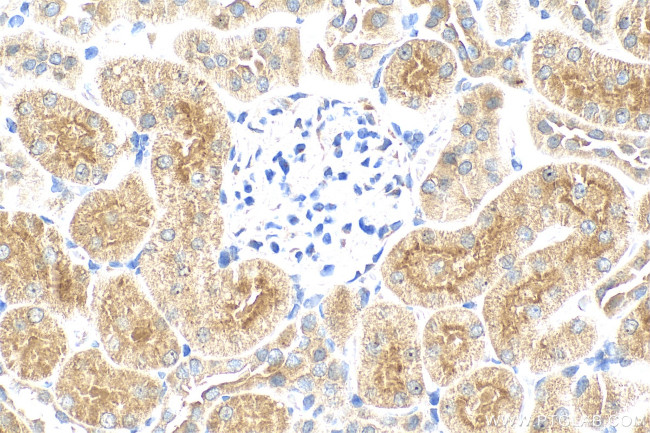
Osteoprotegerin/TNFRSF11B Antibody in Immunohistochemistry (Paraffin) (IHC (P))

Search
Proteintech
Osteoprotegerin/TNFRSF11B Recombinant Rabbit Monoclonal Antibody (240168E9)
{{$productOrderCtrl.translations['antibody.pdp.commerceCard.promotion.promotions']}}
{{$productOrderCtrl.translations['antibody.pdp.commerceCard.promotion.viewpromo']}}
{{$productOrderCtrl.translations['antibody.pdp.commerceCard.promotion.promocode']}}: {{promo.promoCode}} {{promo.promoTitle}} {{promo.promoDescription}}. {{$productOrderCtrl.translations['antibody.pdp.commerceCard.promotion.learnmore']}}
图: 1 / 4
Osteoprotegerin/TNFRSF11B Antibody (83506-1-RR) in IHC (P)




产品信息
83506-1-RR
种属反应
宿主/亚型
Expression System
分类
类型
克隆号
抗原
偶联物
形式
浓度
纯化类型
保存液
内含物
保存条件
运输条件
产品详细信息
Immunogen sequence: MNNLLCCALV FLDISIKWTT QETFPPKYLH YDEETSHQLL CDKCPPGTYL KQHCTAKWKT VCAPCPDHYY TDSWHTSDEC LYCSPVCKEL QYVKQECNRT HNRVCECKEG RYLEIEFCLK HRSCPPGFGV VQAGTPERNT VCKRCPDGFF SNETSSKAPC RKHTNCSVFG LLLTQKGNAT HDNICSGNSE STQKCG
靶标信息
The protein encoded by this gene is a member of the TNF-receptor superfamily. This protein is an osteoblast-secreted decoy receptor that functions as a negative regulator of bone resorption. This protein specifically binds to its ligand, osteoprotegerin ligand, both of which are key extracellular regulators of osteoclast development. Studies of the mouse counterpart also suggest that this protein and its ligand play a role in lymph-node organogenesis and vascular calcification. Alternatively spliced transcript variants of this gene have been reported, but their full length nature has not been determined.
仅用于科研。不用于诊断过程。未经明确授权不得转售。
篇参考文献 (0)
生物信息学
蛋白别名: MGC29565; Osteoclastogenesis inhibitory factor; Osteoprotegerin; soluble OPG; soluble Osteoprotegerin; sOPG; Tumor necrosis factor receptor superfamily member 11B; tumor necrosis factor receptor superfamily, member 11b
基因别名: OCIF; OPG; PDB5; TNFRSF11B; TR1
UniProt ID: (Human) O00300, (Rat) O08727
Entrez Gene ID: (Human) 4982, (Rat) 25341